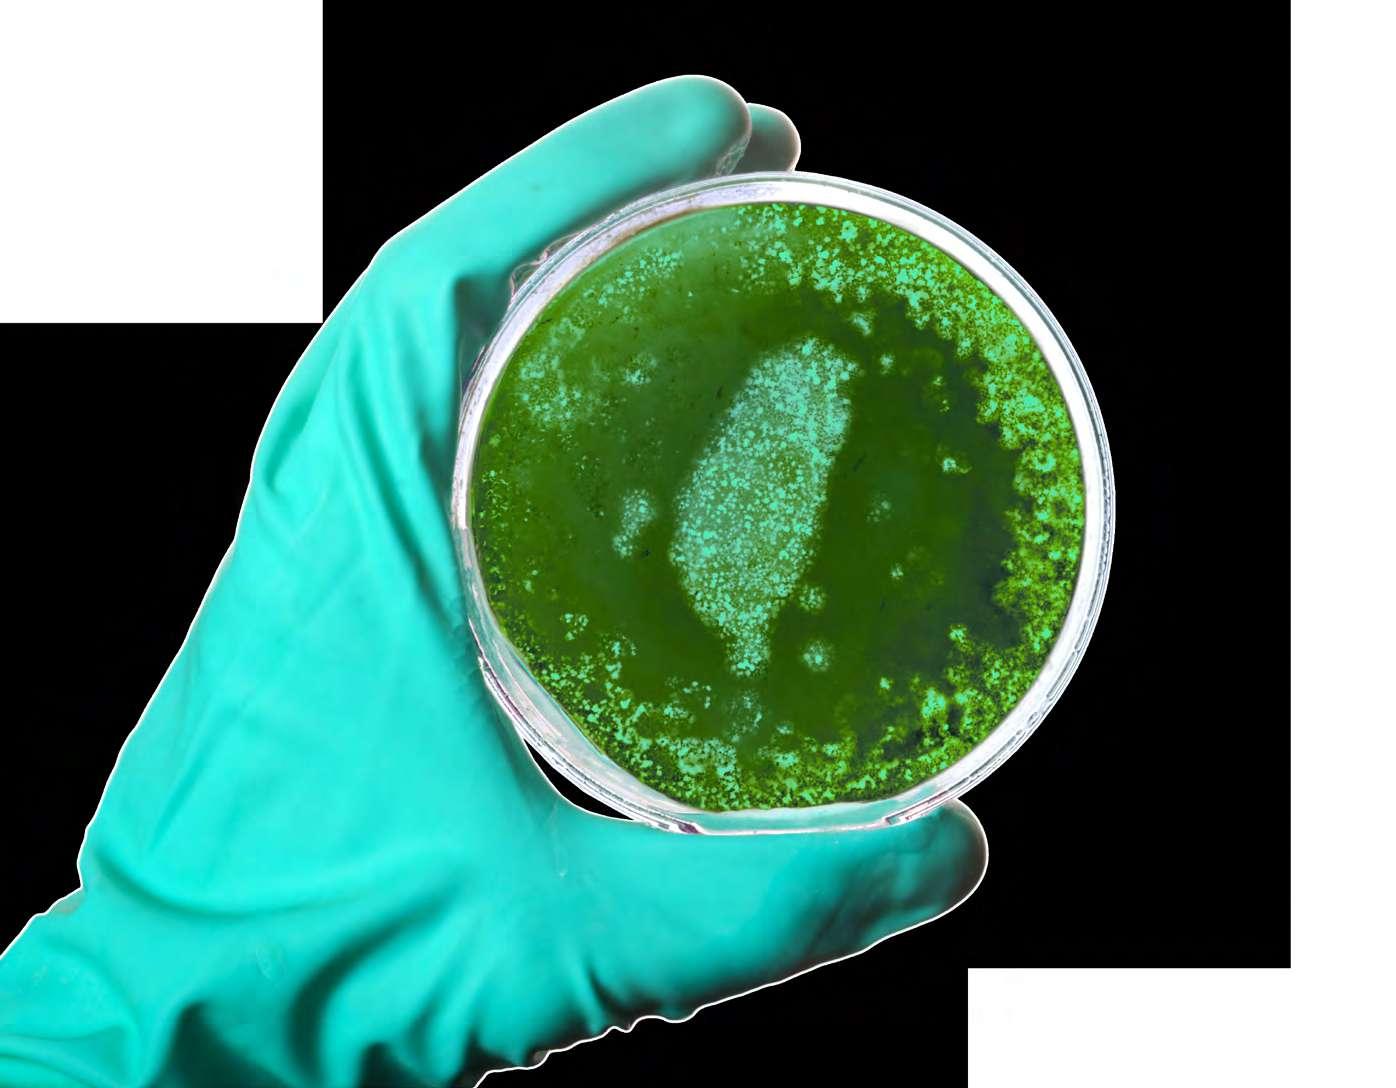

Taiwan Products Magazine is available in both paperback and online.
For downloading the publication, please visit:
https://en.calameo.com/taiwanproducts
https://issuu.com/taiwanproducts
Request for printed copy: bookstore@taitra.org.tw
Contact us: e-member@taitra.org.tw